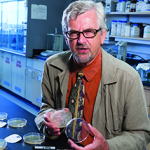
photo of Marcin Filutowicz holding a petri dish

Scientific Patterning
In addition to the images below, there are other science concepts represented in the mural patterning. Can you find them all?
Environmental/Ecology: Abstract landscape background inspired by WI driftless region, abstract murmuration in bands of color& QR patterning in sky
Cell biology: Cell membrane, mitochondria
Molecular biology: Transcription/translation, DNA break (repair/precision medicine)
Microbiology/Microbiome: Poly-microbial community, rhizosphere on plant roots, virology elements (RNA replication machinery, bacteriophage lambda on bacteria)
Computational/Data Science: Computer circuitboard, dovetails with machine learning through interplay with adjacent neurons, computational nodes/networks
Health sciences: Various cell types (neurons, keratinocytes, cell membrane, goblet cells), cardiology (anatomical heartin cell membrane patterning), neuroscience (neurons),vascular biology (branching arteries)
Plant pathology/botany: phloem cross section by Esther Lederberg’s forehead
Food science/Dairy science: Cheese wedge
Nutritional sciences/Pharmaceutical development: VitaminA and Warfarin molecules under large microscope
Limnology: Mendota topographical map in yellow under cell membrane, Lake Mendota & Monona outline in book, Secchi disk next to book
Organization of scientific thought: Node diagram, phylogenetic tree/species classification (this can also reference zebrafish as it resembles fish fin)
Common scientific tools: 96 well plate, micro centrifuge tubes, hidden pipettes

mRNA poly A tail

Edmonds was known for her research in mRNA processing, specifically on 3′-end processing and how RNA is spliced.[3] Her research showed that the end of mRNA is a poly-A tail composed of multiple adenosine residues. In her memoirs posted at the National Academy of Sciences, her work discovering the poly-A tails on eukaryotic mRNA and purification of the poly-A polymerase enzyme are described as “landmarks in the field”.

Viral RNA replication complex in mitochondria wall vesicles

Ahlquist leads the John and Jeanne Rowe Center for Research in Virology at the Morgridge Institute and is the Kaesberg Professor of Oncology, Molecular Virology and Plant Pathology, the Steenbock Professor of Microbiological Sciences, and the Associate Director for Basic Sciences at the UW Carbone Cancer Center. The Ahlquist Lab studies the molecular mechanisms of viral replication, virus-host interactions and viral pathogenesis, including virus-induced cancers.

Replica plating

Joshua Lederberg won the 1958 Nobel Prize in medicine for their work discovering sharing of genes in bacteria. Esther Lederberg’s substantial contributions to this effort received little recognition. In 1952, they performed an experiment using a cloth to “stamp” colonies on plates that helped show that many mutations are random, not directed.

Warfarin molecule

Most of Link’s research focused on plant carbohydrates. However, Ed Carson, a Wisconsin farmer, attracted Link’s attention to “sweet clover disease”, wherein cows bled to death after consuming hay made from spoilt sweet clover because the cow’s blood would not clot. Link and his assistants crystallized the putative poison—a coumarin-related compound which turned out to be dicoumarol. This eventually was patented as Warfarin in 1945 by the Wisconsin Alumni Research Foundation (WARF). It became WARF’s first patent.

Vitamin A molecule

Marguerite Davis discovered Vitamin A in 1913 as an unpaid assistant researcher to Elmer Verner McCollum. (McCollom’s requests for her salary were denied until her final year in his lab.) She founded the nutrition laboratory at the University of Wisconsin. She subsequently worked for the Squibb Pharmaceutical Company in New Jersey and later helped Rutgers University form a nutrition lab as part of its Ernest Mario School of Pharmacy. In 1940, she returned to the University of Wisconsin to teach and do research.

Bacterial conjugation
Bacterial conjugation is the transfer of genetic material between bacterial cells by direct cell-to-cell contact or by a bridge-like connection between two cells. This takes place through a pilus (a hair-like appendage found on the surface of many bacteria). It is a parasexual mode of reproduction in bacteria. Marcin Filutowicz was full professor in the Department of Bacteriology at UW–Madison. His academic career was devoted to studying basic processes of DNA replication. He developed highly innovative approaches to combat infectious agents by harnessing the natural antibiotic properties of non-pathogenic microbes using bacterial conjugation. He founded three biotechnology companies.